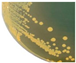
Foods 13 02375 i001
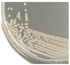
Foods 13 02375 i002
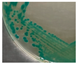
Foods 13 02375 i006
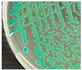
Foods 13 02375 i008
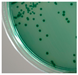
Foods 13 02375 i009

Multidrug-Resistance of Vibrio Species in Bivalve Mollusks from Southern Thailand: Isolation, Identification, Pathogenicity, and Their Sensitivity toward Chitooligosaccharide-Epigallocatechin-3-Gallate Conjugate
Abstract
1. Introduction
2. Materials and Methods
2.1. Chemical and Microbial Media
2.2. Sample Collection and Vibrio Isolation
2.3. Classification and Identification of Vibrio
2.4. Pathogenicity Detection of Vibrio Isolates
2.5. Biofilm Formation
2.6. Detection of Virulence Genes
2.7. Antibiotic Susceptibility
2.8. Bacterial Identification
2.9. Effect of COS-EGCG Conjugate on Inhibition of MDR Vibrio Strains
2.9.1. Preparation of COS-EGCG Conjugate
2.9.2. Minimum Inhibitory Concentration (MIC) and Minimum Bactericidal Concentration (MBC)
2.9.3. Scanning Electron Microscopy (SEM)
2.10. Statistical Analysis
3. Results and Discussion
3.1. Morphological Identification of Vibrio spp. Colonies
3.2. Hemolysis
3.3. Presence of Virulence Gene
3.4. Biofilm Formation
3.5. Antibiotic Resistance of Selected Isolates
3.6. Molecular Identification Using 16s rRNA Gene Sequencing
3.7. Antimicrobial Activity of COS-EGCG Conjugate against Multidrug-Resistant (MDR) Vibrio Strains
4. Conclusions
Author Contributions
Funding
Institutional Review Board Statement
Informed Consent Statement
Data Availability Statement
Acknowledgments
Conflicts of Interest
References
- Janekrongtham, C.; Dejburum, P.; Sujinpram, S.; Rattanathumsakul, T.; Swaddiwudhipong, W. Outbreak of seafood-related food poisoning from undetectable Vibrio parahaemolyticus -like pathogen, Chiang Mai province, Thailand, December 2020. Trop. Med. Int. Health 2022, 27, 92–98. [Google Scholar] [CrossRef] [PubMed]
- Ali, A.; Parisi, A.; Conversano, M.C.; Iannacci, A.; D’Emilio, F.; Mercurio, V.; Normanno, G. Food-borne bacteria associated with seafoods: A Brief Review. JFQHC 2020. [Google Scholar] [CrossRef]
- Lee, H.; Yoon, Y. Etiological agents implicated in foodborne illness world wide. Food Sci. Anim. Resour. 2021, 41, 1–7. [Google Scholar] [CrossRef] [PubMed]
- Thompson, F.L.; Gevers, D.; Thompson, C.C.; Dawyndt, P.; Naser, S.; Hoste, B.; Munn, C.B.; Swings, J. Phylogeny and molecular identification of Vibrios on the basis of multilocus sequence analysis. Appl. Environ. Microbiol. 2005, 71, 5107–5115. [Google Scholar] [CrossRef] [PubMed]
- Elhadi, N.; Radu, S.; Chen, C.-H.; Nishibuchi, M. Prevalence of potentially pathogenic Vibrio species in the seafood marketed in Malaysia. J. Food Prot. 2004, 67, 1469–1475. [Google Scholar] [CrossRef] [PubMed]
- Santajit, S.; Kong-ngoen, T.; Tunyong, W.; Pumirat, P.; Ampawong, S.; Sookrung, N.; Indrawattana, N. Occurrence, antimicrobial resistance, virulence, and biofilm formation capacity of Vibrio Spp. and Aeromonas Spp. isolated from raw seafood marketed in Bangkok, Thailand. Vet. World 2022, 15, 1887–1895. [Google Scholar] [CrossRef] [PubMed]
- Bonnin-Jusserand, M.; Copin, S.; Le Bris, C.; Brauge, T.; Gay, M.; Brisabois, A.; Grard, T.; Midelet-Bourdin, G. Vibrio species involved in seafood-borne outbreaks (Vibrio cholerae, V. parahaemolyticus and V. vulnificus): Review of microbiological versus recent molecular detection methods in seafood products. Crit. Rev. Food Sci. Nutr. 2019, 59, 597–610. [Google Scholar] [CrossRef] [PubMed]
- Devi, A.R.; Susilowati, A. Ratna Setyaningsih Morphology, molecular identification, and pathogenicity of Vibrio spp. on blood clam (Anadara granosa) in Yogyakarta, Indonesia tourism beach areas. Biodiversitas 2019, 20. [Google Scholar] [CrossRef]
- He, X.Q.; Cao, W.H.; Pan, G.K.; Yang, L.; Zhang, C.H. Enzymatic hydrolysis optimization of Paphia undulata and lymphocyte proliferation activity of the isolated peptide fractions. J. Sci. Food Agric. 2015, 95, 1544–1553. [Google Scholar] [CrossRef]
- Ma, Z.; Fu, Z.; Yang, J.; Yu, G. Combined effects of temperature and salinity affect the survival of Asian green mussel (Perna Viridis) through digestive and antioxidant performance. Antioxidants 2022, 11, 2009. [Google Scholar] [CrossRef]
- Yu, M.; Zheng, L.; Wang, X.; Wu, M.; Qi, M.; Fu, W.; Zhang, Y. Comparative transcriptomic analysis of surf clams (Paphia undulate) infected with two strains of Vibrio spp. reveals the identity of key immune genes involved in host defense. BMC Genom. 2019, 20, 988. [Google Scholar] [CrossRef] [PubMed]
- Thongchan, J.; Bhoopong, P.; Yingkajorn, M.; Nishibuchi, M.; Vuddhakul, V. Total number, virulence genes, and heterogeneity of Vibrio parahaemolyticus in a single shellfish. ScienceAsia 2013, 39, 230. [Google Scholar] [CrossRef]
- Bao, Y.; Wang, Q.; Lin, Z. Hemoglobin of the bloody clam Tegillarca granosa (Tg-HbI) is involved in the immune response against bacterial infection. Fish Shellfish. Immunol. 2011, 31, 517–523. [Google Scholar] [CrossRef] [PubMed]
- Palamae, S.; Mittal, A.; Yingkajorn, M.; Saetang, J.; Buatong, J.; Tyagi, A.; Singh, P.; Benjakul, S. Vibrio parahaemolyticus isolates from Asian green mussel: Molecular characteristics, virulence and their inhibition by chitooligosaccharide-tea polyphenol conjugates. Foods 2022, 11, 4048. [Google Scholar] [CrossRef] [PubMed]
- Ahmed, H.A.; El Bayomi, R.M.; Hussein, M.A.; Khedr, M.H.E.; Abo Remela, E.M.; El-Ashram, A.M.M. Molecular characterization, antibiotic resistance pattern and biofilm formation of Vibrio parahaemolyticus and V. cholerae isolated from crustaceans and humans. Int. J. Food Microbiol. 2018, 274, 31–37. [Google Scholar] [CrossRef]
- Mittal, A.; Singh, A.; Zhang, B.; Visessanguan, W.; Benjakul, S. Chitooligosaccharide conjugates prepared using several phenolic compounds via ascorbic acid/H2O2 free radical grafting: Characteristics, antioxidant, antidiabetic, and antimicrobial activities. Foods 2022, 11, 920. [Google Scholar] [CrossRef]
- Singh, A.; Benjakul, S.; Huda, N.; Xu, C.; Wu, P. Preparation and characterization of squid pen chitooligosaccharide–epigallocatechin gallate conjugates and their antioxidant and antimicrobial activities. RSC Adv. 2020, 10, 33196–33204. [Google Scholar] [CrossRef]
- Buatong, J.; Mittal, A.; Mittraparp-arthorn, P.; Palamae, S.; Saetang, J.; Benjakul, S. Bactericidal action of shrimp shell chitooligosaccharide conjugated with epigallocatechin gallate (COS-EGCG) against Listeria monocytogenes. Foods 2023, 12, 634. [Google Scholar] [CrossRef]
- Schwartz, K.; Kukuc, C.; Bier, N.; Taureck, K.; Hammerl, J.A.; Strauch, E. Diversity of Vibrio navarrensis revealed by genomic comparison: Veterinary isolates are related to strains associated with human illness and sewage isolates while seawater strains are more distant. Front. Microbiol. 2017, 8, 1717. [Google Scholar] [CrossRef]
- Beshiru, A.; Igbinosa, E.O. Surveillance of Vibrio parahaemolyticus pathogens recovered from ready-to-eat foods. Sci. Rep. 2023, 13, 4186. [Google Scholar] [CrossRef]
- Moussa, M.; Cauvin, E.; Le Piouffle, A.; Lucas, O.; Bidault, A.; Paillard, C.; Benoit, F.; Thuillier, B.; Treilles, M.; Travers, M.A.; et al. A MALDI-TOF MS database for fast identification of Vibrio spp. potentially pathogenic to marine mollusks. Appl. Microbiol. Biotechnol. 2021, 105, 2527–2539. [Google Scholar] [CrossRef]
- Wang, L.; Ling, Y.; Jiang, H.; Qiu, Y.; Qiu, J.; Chen, H.; Yang, R.; Zhou, D. AphA is required for biofilm formation, motility, and virulence in pandemic Vibrio parahaemolyticus. Int. J. Food Microbiol. 2013, 160, 245–251. [Google Scholar] [CrossRef]
- Han, N.; Mizan, M.d.F.R.; Jahid, I.K.; Ha, S.-D. Biofilm formation by Vibrio parahaemolyticus on food and food contact surfaces increases with rise in temperature. Food Control 2016, 70, 161–166. [Google Scholar] [CrossRef]
- Lucero-Mejía, J.E.; Romero-Gómez, S.D.J.; Hernández-Iturriaga, M. A New Classification criterion for the biofilm formation index: A study of the biofilm dynamics of pathogenic Vibrio species isolated from seafood and food contact surfaces. J. Food Sci. 2020, 85, 2491–2497. [Google Scholar] [CrossRef]
- Siddique, A.B.; Moniruzzaman, M.; Ali, S.; Dewan, M.d.N.; Islam, M.R.; Islam, M.d.S.; Amin, M.B.; Mondal, D.; Parvez, A.K.; Mahmud, Z.H. Characterization of pathogenic Vibrio parahaemolyticus isolated from fish aquaculture of the Southwest coastal area of Bangladesh. Front. Microbiol. 2021, 12, 635539. [Google Scholar] [CrossRef]
- Shaw, K.S.; Rosenberg Goldstein, R.E.; He, X.; Jacobs, J.M.; Crump, B.C.; Sapkota, A.R. Antimicrobial susceptibility of Vibrio vulnificus and Vibrio parahaemolyticus recovered from recreational and commercial areas of Chesapeake Bay and Maryland Coastal Bays. PLoS ONE 2014, 9, e89616. [Google Scholar] [CrossRef] [PubMed]
- CLSI. CLSI Document M45—Methods for Antimicrobial Dilution and Disk Susceptibility Testing of Infrequently Isolated or Fastidious Bacteria, 3rd ed.; CLSI: Wayne, PA, USA, 2018. [Google Scholar]
- Pascual, J.; Macián, M.C.; Arahal, D.R.; Garay, E.; Pujalte, M.J. Multilocus sequence analysis of the central clade of the genus Vibrio by using the 16s rrna, reca, pyrh, rpod, gyrb, rctb and toxr genes. Int. J. Syst. Evol. Microbiol. 2010, 60, 154–165. [Google Scholar] [CrossRef]
- Tamura, K.; Stecher, G.; Peterson, D.; Filipski, A.; Kumar, S. MEGA6: Molecular evolutionary genetics analysis version 6.0. Mol. Biol. Evol. 2013, 30, 2725–2729. [Google Scholar] [CrossRef] [PubMed]
- Dieckmann, R.; Strauch, E.; Alter, T. Rapid identification and characterization of Vibrio species using whole-cell MALDI-TOF mass spectrometry. J. Appl. Microbiol. 2010, 109, 199–211. [Google Scholar] [CrossRef]
- Dahanayake, P.S.; Hossain, S.; Wickramanayake, M.V.K.S.; Wimalasena, S.H.M.P.; Heo, G.-J. Manila clam ( Ruditapes philippinarum) marketed in Korea as a source of Vibrios harbouring virulence and β-lactam resistance genes. Lett. Appl. Microbiol. 2020, 71, 46–53. [Google Scholar] [CrossRef]
- Hikmawati, F.; Susilowati, A. Ratna Setyaningsih Colony morphology and molecular identification of Vibrio spp. on Green mussels (Perna viridis) in Yogyakarta, Indonesia Tourism Beach Areas. Biodiversitas 2019, 20. [Google Scholar] [CrossRef]
- Zhang, X.-H.; Austin, B. Haemolysins in Vibrio species. J. Appl. Microbiol. 2005, 98, 1011–1019. [Google Scholar] [CrossRef] [PubMed]
- Mogrovejo, D.C.; Perini, L.; Gostinčar, C.; Sepčić, K.; Turk, M.; Ambrožič-Avguštin, J.; Brill, F.H.H.; Gunde-Cimerman, N. Prevalence of antimicrobial resistance and hemolytic phenotypes in culturable arctic bacteria. Front. Microbiol. 2020, 11, 570. [Google Scholar] [CrossRef] [PubMed]
- Dong, Y.; Zhao, P.; Chen, L.; Wu, H.; Si, X.; Shen, X.; Shen, H.; Qiao, Y.; Zhu, S.; Chen, Q.; et al. Fast, simple and highly specific molecular detection of Vibrio alginolyticus pathogenic strains using a visualized isothermal amplification method. BMC Vet. Res. 2020, 16, 76. [Google Scholar] [CrossRef]
- Raghunath, P. Roles of thermostable direct hemolysin (TDH) and TDH-related hemolysin (TRH) in Vibrio parahaemolyticus. Front. Microbiol. 2015, 5, 805. [Google Scholar] [CrossRef] [PubMed]
- Wang, R.; Zhong, Y.; Gu, X.; Yuan, J.; Saeed, A.F.; Wang, S. The pathogenesis, detection, and prevention of Vibrio parahaemolyticus. Front. Microbiol. 2015, 6, 144. [Google Scholar] [CrossRef] [PubMed]
- Malcolm, T.T.H.; Cheah, Y.K.; Radzi, C.W.J.W.M.; Kantilal, H.K.; Martinez-Urtaza, J.; Nishibuchi, M.; Son, R. Microbial Risk Assessment of Vibrio parahaemolyticus in bloody clams in Malaysia: A preliminary model from retail to consumption. Microb. Risk Anal. 2016, 4, 43–51. [Google Scholar] [CrossRef]
- Tan, C.W.; Rukayadi, Y.; Hasan, H.; Thung, T.Y.; Lee, E.; Rollon, W.D.; Hara, H.; Kayali, A.Y.; Nishibuchi, M.; Radu, S. Prevalence and antibiotic resistance patterns of Vibrio parahaemolyticus isolated from different types of seafood in Selangor, Malaysia. Saudi J. Biol. Sci. 2020, 27, 1602–1608. [Google Scholar] [CrossRef]
- Verderosa, A.D.; Totsika, M.; Fairfull-Smith, K.E. Bacterial biofilm eradication agents: A current review. Front. Chem. 2019, 7, 824. [Google Scholar] [CrossRef]
- Liu, X.; Yao, H.; Zhao, X.; Ge, C. Biofilm formation and control of foodborne pathogenic bacteria. Molecules 2023, 28, 2432. [Google Scholar] [CrossRef]
- Vestby, L.K.; Grønseth, T.; Simm, R.; Nesse, L.L. Bacterial biofilm and its role in the pathogenesis of disease. Antibiotics 2020, 9, 59. [Google Scholar] [CrossRef]
- Gxalo, O.; Digban, T.O.; Igere, B.E.; Olapade, O.A.; Okoh, A.I.; Nwodo, U.U. Virulence and antibiotic resistance characteristics of Vibrio isolates from rustic environmental freshwaters. Front. Cell. Infect. Microbiol. 2021, 11, 732001. [Google Scholar] [CrossRef] [PubMed]
- Abdulhakeem, M.A.; Alreshidi, M.; Bardakci, F.; Hamadou, W.S.; De Feo, V.; Noumi, E.; Snoussi, M. Molecular identification of bacteria isolated from marketed Sparus aurata and Penaeus indicus sea products: Antibiotic resistance profiling and evaluation of biofilm formation. Life 2023, 13, 548. [Google Scholar] [CrossRef]
- Abebe, G.M. The role of bacterial biofilm in antibiotic resistance and food contamination. Int. J. Microbiol. 2020, 2020, 1705814. [Google Scholar] [CrossRef] [PubMed]
- Ramamurthy, T.; Chowdhury, G.; Pazhani, G.P.; Shinoda, S. Vibrio fluvialis: An emerging human pathogen. Front. Microbiol. 2014, 5, 91. [Google Scholar] [CrossRef] [PubMed]
- Igbinosa, E.O.; Okoh, A.I. Vibrio fluvialis: An unusual enteric pathogen of increasing public health concern. IJERPH 2010, 7, 3628–3643. [Google Scholar] [CrossRef]
- Kong, C.; Zhang, H.; Li, L.; Liu, Z. Effects of green tea extract epigallocatechin-3-gallate (EGCG) on oral disease-associated microbes: A Review. J. Oral. Microbiol. 2022, 14, 2131117. [Google Scholar] [CrossRef] [PubMed]
- Pei, J.; Yu, H.; Qiu, W.; Mei, J.; Xie, J. Antimicrobial effect of epigallocatechin gallate against Shewanella putrefaciens ATCC 8071: A study based on cell membrane and biofilm. Curr. Microbiol. 2022, 79, 297. [Google Scholar] [CrossRef]
- Liaqat, F.; Eltem, R. Chitooligosaccharides and their biological activities: A comprehensive review. Carbohydr. Polym. 2018, 184, 243–259. [Google Scholar] [CrossRef]






| Target Genes | Primers | Sequence (5’-3’) | Amplicon Size (bp) | References |
|---|---|---|---|---|
| tdh | tdh-F | GTAAAGGTCTCTGACTTTTGGAC | 269 | Siddique et al. (2021) [25] |
| tdh-R | TGGAATAGAACCTTCATCTTCACC | |||
| tlh | tlh-F | AAAGCGGATTATGCAGAAGCACTG | 450 | |
| tlh-R | GCTACTTTCTAGCATTTTCTCTGC | |||
| trh | trh-F | TTGGCTTCGATATTTTCAGTATCT | 500 | |
| trh-R | CATAACAAACATATGCCCATTTCCG | |||
| 16s rRNA | 27F | AGAGTTTGATCCTGGCTCAG | 1400 | Palamae et al. (2022) [14] |
| 1429R | GGTTACCTTGTTACGACTT |
| TCBS | HiCromeTM Vibrio | MALDI Biotyper® Analysis | BL | BB | M | Total of Each Character |
|---|---|---|---|---|---|---|
Yellow![]() | Creamy white![]() | V. navarrensis | 82 | 44 | 12 | 138 |
Yellow![]() | Indigo/Purple![]() | V. fluvialis | 49 | 0 | 15 | 64 |
Yellow![]() | Light green ![]() | V. alginolyticus | 123 | 80 | 7 | 210 |
Green![]() | Light green![]() | V. parahaemolyticus | 73 | 41 | 47 | 161 |
Green![]() | Purple![]() | V. vunificus | 14 | 22 | 0 | 36 |
Green![]() | Creamy white![]() | V. harveyi | 16 | 21 | 3 | 40 |
| Total | 649 | |||||
| Vibrio Strains | Species |
|---|---|
| BL2, BL48, BL56, BL87, BL95, BL99, BB73, BB103, M69, BL133 | Vibrio alginolyticus |
| BL105, M34, M68, M105 | Vibrio navarrensis |
| BL186 | Vibrio fluvialis |
| BL18, BL82, BL84, BL85, BL90, BL92 | Vibrio parahaemolyticus |
| Antibiotics | Concentration (µg/mL) | Vibrio Strains | |||||||
|---|---|---|---|---|---|---|---|---|---|
| BL2, BL18, BL48, BL82, BL87, BL90, BL92, BL95, BL133, M68, M69 | BL56, BL84, BL85, BB103 | BB73 | BL99 | BL105 | BL186 | M34 | M105 | ||
| AN | 8–32 | S | S | S | S | S | S | S | S |
| AMC | 4/2–16/8 | S | S | S | S | I | R | I | I |
| AM | 8–16 | NI | NI | NI | NI | NI | NI | NI | NI |
| SAM | 4/2–16/8 | S | S | S | S | I | R | I | I |
| FEP | 1–32 | S | S | S | S | S | S | I | S |
| CTX | 1–32 | S | S | S | R | R | R | R | R |
| FOX | 4–16 | NI | NI | NI | NI | NI | NI | NI | NI |
| CAZ | 1–32 | S | S | S | S | S | S | S | S |
| CRO | 0.5–32 | NI | NI | NI | NI | NI | NI | NI | NI |
| CXM | 8–16 | S | I | NM | R | R | R | R | R |
| CIP | 0.06–2 | S | S | S | S | S | S | S | S |
| CL | 1–8 | NI | NI | NI | NI | NI | NI | NI | NI |
| DOR | 0.5–16 | NI | NI | NI | NI | NI | NI | NI | NI |
| ETP | 0.5–4 | NI | NI | NI | NI | NI | NI | NI | NI |
| GM | 2–8 | S | S | S | S | S | S | S | S |
| IPM | 0.5–16 | S | S | S | S | S | S | S | S |
| LVX | 0.06–8 | S | S | S | S | S | S | S | S |
| MEM | 0.5–16 | S | S | S | S | S | R | S | S |
| NET | 8–16 | NI | NI | NI | NI | NI | NI | NI | NI |
| TZP | 8/4–64/4 | S | S | S | S | S | S | S | S |
| SXT | 1/19–4/76 | S | S | S | S | S | R | S | S |
| Vibrio Strains | MIC (µg/mL) | MBC (µg/mL) | MBC/MIC Ratio |
|---|---|---|---|
| Vibrio neocaledonicus BL99 | 128 | 128 | 1 |
| Vibrio cidicii BL105 | 64 | 128 | 2 |
| Vibrio fluvialis BL186 | 64 | 64 | 1 |
| Vibrio cidicii M34 | 128 | 128 | 1 |
| Vibrio cidicii M105 | 64 | 64 | 1 |
Disclaimer/Publisher’s Note: The statements, opinions and data contained in all publications are solely those of the individual author(s) and contributor(s) and not of MDPI and/or the editor(s). MDPI and/or the editor(s) disclaim responsibility for any injury to people or property resulting from any ideas, methods, instructions or products referred to in the content. |
© 2024 by the authors. Licensee MDPI, Basel, Switzerland. This article is an open access article distributed under the terms and conditions of the Creative Commons Attribution (CC BY) license (https://creativecommons.org/licenses/by/4.0/).
Share and Cite
Sharma, M.H.; Palamae, S.; Yingkajorn, M.; Benjakul, S.; Singh, A.; Buatong, J. Multidrug-Resistance of Vibrio Species in Bivalve Mollusks from Southern Thailand: Isolation, Identification, Pathogenicity, and Their Sensitivity toward Chitooligosaccharide-Epigallocatechin-3-Gallate Conjugate. Foods 2024, 13, 2375. https://doi.org/10.3390/foods13152375
Sharma MH, Palamae S, Yingkajorn M, Benjakul S, Singh A, Buatong J. Multidrug-Resistance of Vibrio Species in Bivalve Mollusks from Southern Thailand: Isolation, Identification, Pathogenicity, and Their Sensitivity toward Chitooligosaccharide-Epigallocatechin-3-Gallate Conjugate. Foods. 2024; 13(15):2375. https://doi.org/10.3390/foods13152375
Chicago/Turabian StyleSharma, Mruganxi Harshad, Suriya Palamae, Mingkwan Yingkajorn, Soottawat Benjakul, Avtar Singh, and Jirayu Buatong. 2024. "Multidrug-Resistance of Vibrio Species in Bivalve Mollusks from Southern Thailand: Isolation, Identification, Pathogenicity, and Their Sensitivity toward Chitooligosaccharide-Epigallocatechin-3-Gallate Conjugate" Foods 13, no. 15: 2375. https://doi.org/10.3390/foods13152375
APA StyleSharma, M. H., Palamae, S., Yingkajorn, M., Benjakul, S., Singh, A., & Buatong, J. (2024). Multidrug-Resistance of Vibrio Species in Bivalve Mollusks from Southern Thailand: Isolation, Identification, Pathogenicity, and Their Sensitivity toward Chitooligosaccharide-Epigallocatechin-3-Gallate Conjugate. Foods, 13(15), 2375. https://doi.org/10.3390/foods13152375